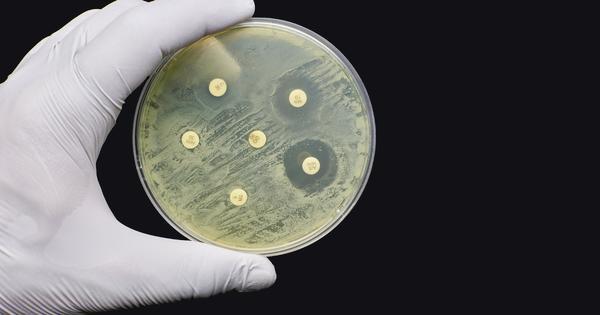
Hand holding up a petri dish of antimicrobial susceptibility resistance test by diffusion

Antimicrobial resistance – the slow pandemic
The College was delighted that Professor Dame Sally Davies, UK Antimicrobial Resistance Special Envoy to the UN, gave one of the flagship Diamond Jubilee lectures on the subject ‘Antimicrobial resistance – the slow pandemic’ at the UK Federation of Infection Societies meeting in September 2022.
With Dame Sally’s permission, we have reproduced her Diamond Jubilee lecture abstract and selected excerpts for our members and Fellows who were not in attendance.
Abstract
Lives, livelihoods and health inequities have been exacerbated by COVID-19. All the while, the world is facing a slower pandemic of antimicrobial resistance (AMR), with new data confirming that AMR is now the third-leading underlying cause of death globally, with disproportionate impacts on the most vulnerable demographics.
Yet, the World Health Organization (WHO) deem that ‘the world is failing on AMR’ because of the lack of treatments in development that will fill critical public health needs. During this keynote, Dame Sally Davies discussed how policymakers, healthcare workers and the public can learn from COVID-19 to increase innovation, access and stewardship of antimicrobial treatments globally. She shared innovative solutions that are being trialled across the world, from surveillance apps to behavioural nudge theory, and even a musical about Alexander Fleming to raise public awareness.
AMR is now the third-leading underlying cause of death globally, with disproportionate impacts on the most vulnerable demographics.
Excerpts from Dame Sally’s lecture
What I thought might be useful to you was to tell you the story of how I became aware of AMR, how I got into it, how I have worked with policy to highlight it, and why I continue as the special envoy for His Majesty’s Government as well as having a full-time job as Master of Trinity College, Cambridge. I do want to emphasise to you that you are the experts. What I do is always supported by experts because I know I am not a microbiologist.
Early introductions to AMR
I started in a district general hospital as a haematologist at Central Middlesex, working on sickle cell disease, and I did see AMR then. If you were a lay audience, I would give you a couple of stories of patients who died through AMR from that period. But you have got your own stories; you do not need my stories. In general, in that period, the microbiologist would come along and say ‘resistant infection, swap to this’, and it was all fine.
I moved on into research. I thought up, set up and ran the National Institute for Health and Care Research (NIHR), and then in 2010 became the Chief Medical Officer (CMO). One of the interesting things about being CMO was that you have to write an independent annual report on anything you want. The way I did these reports was different from previous CMOs. I chose the subject, I chose the experts and I got them together. They wrote their chapters and then we had a day thinking, "what does this all mean for policy?" I then wrote the policy chapter.
Understanding the problem of AMR
My second report was what we called an advocacy report. I chose antimicrobial-resistant infections. It was published on 11 March 2013, so I think we are going to have a party on 11 March 2023 to celebrate 10 years of hard work on AMR! One of the things that hit me was that we were in a mess.
There we were, in 2013, and AMR was getting worse and worse. We had an empty pipeline. We had market failure because we were not paying enough for the drugs – it takes 20 years to develop a drug. So, we were essentially in a mess. The words I used on that day were "I will give this problem a voice".
I began to understand that this was not just a human problem. This went into animals and the food chain and, I have since discovered, the environment too. I do not think I quite understood the complexity at that point. I had not understood about the different thinking as you go forward into the One Health area that comes from the profit motive. I had understood market failure, but the profit motive in the food chain and the environment I only came to much later.
People talk in the animal sector or the food sector differently from the human sector. We talk about infection prevention and control; they talk about biosecurity. You all know that over 70% of antibiotics go to animals, a lot of it for growth promotion; you all know that there is a direct relationship between overuse, or use, and resistance developing; you know how it is transmitted better than I do, and you know that Fleming predicted it.
Every time I lift a stone up, I find another problem. We have to find a way to share language, to get people to do things that will make an impact.
What do we do?
So, what do we do about this overuse? There is poor use, but there is also poor access in some places in the world, so we have this ‘excess’ versus ‘access’ balancing act. In trying to work at the policy level globally, I do recognise the need for access. Access is not just being able to afford it. Over 50% of antibiotics in many of the low-income countries are counterfeit, so there’s a real issue about access and cost and decent drugs, let alone regulation. You all know about poor hygiene. You know we have not had a new class of drugs since the late 80s come into routine use. You know about the food chain. You know about the limited diagnostics and how expensive they are, and how difficult it is to get them used.
I have to say that it feels to me a bit like every time I lift a stone up, I find another problem. We have to find a way to share language, to get people to do things that will make an impact. I actually talk now much more about antibiotics and antimicrobials being core infrastructure for health systems, food systems, health security, food security and actually for environmental security, because what is going into the environment from animals and from manufacturing is actually polluting the environment too, so we have a big problem there.
I was setting out to try and make sure that we really did make an impact as Britain and try and make a difference. The Cabinet Secretary sent me off to the Foreign Office. I still remember sitting in the in the Permanent Secretary’s office. He said: "what you need is good old-fashioned diplomacy" So I said: "I do not know what it is, but I will have it – yes, please!"
They have been totally wonderful because there is a Science and Innovation Network across the world run by our Foreign Office, and they have all picked up AMR. They love it because it is not political, it will save lives, it matters. They have done a terrific amount of work.
On the UK Government’s antibiotic subscription model
Essentially if you want to break the market failure, we have got to pay a proper price for antibiotics. Antibiotics are usually loss leaders. Our team persuaded the NHS to work with NICE and the health economics unit in York to try and evaluate drugs, not in the standard way, but as an insurance. You were getting those people back to work – you were not having to close a ward or a hospital, you were not transmitting it to other people – and looking at the broader societal impact.
Actually, by the time they had done that, they came out with prices which, if done all round the global north, would break the impasse. It would be worth pharma companies being in the business. That was what we were after. Now, the NHS is bringing this ‘pull’ approach into their routine processes.
So, what do we do about this overuse? There is poor use, but there is also poor access in some places in the world, so we have this ‘excess’ versus ‘access’ balancing act.
Lobbying through the United Nations
The UN set up a Global Leaders Group, known as the GLG, which I am a member of. We are advocating for sustained political action for transforming human health, animal health, food, plant and environment ecosystems so they are sustainable and focused on infection prevention and control and responsible sustainable use of antibiotics.
We advocate for improved surveillance and monitoring, mobilising funds to get all of this to happen, increased effective affordable innovations, better understanding of environmental pathways and actually helping poor countries do what the Global North does. We are having some impact.
I have to say, I do not think we are having as much as I had hoped, or wish, or should have, but we are working hard. We have got another high-level meeting at the UN on AMR in 2024, so we now have to think, what do we want out of it? Then, having decided what we want, we have got to work out a roadmap to get there: who are the people we need to take with us, not only the technical people – all of you – but industry, patients, public and food chain too?
The slow pandemic
Another big tranche of work for my colleagues and me is, of course, that the WHO is trying to negotiate a Pandemic Treaty. We argue that it has to contain AMR and recognise One Health issues. AMR is the slow pandemic. Some of you will have heard my metaphor of the lobster – that COVID-19 was like the lobster dropped in boiling water, which makes a lot of noise and dies. AMR is the lobster put (as the RSPCA says you should) into cold water, heating it up slowly; it makes no noise but it will die in the end. There are countries who do not want even the words AMR in the Pandemic Treaty. There are people who do not want it to be One Health.
The WHO is trying to negotiate a Pandemic Treaty. We argue that it has to contain AMR and recognise One Health issues.
I am also on the board of the Institute of Health Metrics and Evaluation (IHME), who have Gates’s biggest grant. What I realised was, if we could get them to work out the AMR burden of disease, we would have some good data that would be useful. So, I started by asking them to do it. Eventually, we persuaded the Fleming Fund, Wellcome Trust and Gates to come together to fund it. It is called the GRAM study; it is led out of Oxford, though it is IHME – you will have seen it and the impact it made last February in The Lancet.1
How do we make it happen?
But how do we make it happen everywhere? How do we get it to be the norm that people think hard about using antimicrobials? That when they prescribe them, they are good quality? That they pay the appropriate price for them, they steward them and they use them for the right period of time (not that I know what the right period of time is)?
When we advertised from NIHR for someone to come in and do studies, we did not get any bids. But, surely, for different infections we do not classically need the 5 days, 7 days, 10 days – we may need shorter or longer and I do not think there is enough evidence.
Pharma has not been a total failure. There are still some companies in antimicrobials and they set up in 2016 an AMR Industry Alliance. They proposed standards for waste effluent. Maybe if we could get those to take off, then we could have a look and see whether we need to get them stricter. But I would love to start with those around the world.
Meanwhile, they set up the 1-billion-dollar AMR action fund, with the intention of bringing 4 new antibiotics through, and that is a significant amount of money. I was invited by 1 of their global business organisations to go to the meeting of the chief execs in Washington. I actually did tell them that they had blood on their hands if they did not do something. I think they were a bit taken aback – but they are doing it. In the end we will have to pay. Every single one of us in this room, every single person across the globe – we pay through insurance, we pay through taxes, we pay out of pocket, we pay through lives lost, but we are going to have to pay. The only question is – what is a reasonable profit?
We do this for people and they need a voice, so we hope that some of this will help us find a voice. In doing all of this, of course, we believe that we can impact on the Sustainable Development Goals, as we absolutely must.
I want to finish here. I want to again thank all of you for the work you do, day in and day out, on infections, on AMR, on helping patients, on helping people. Without you we would be in a mess – so thank you.
